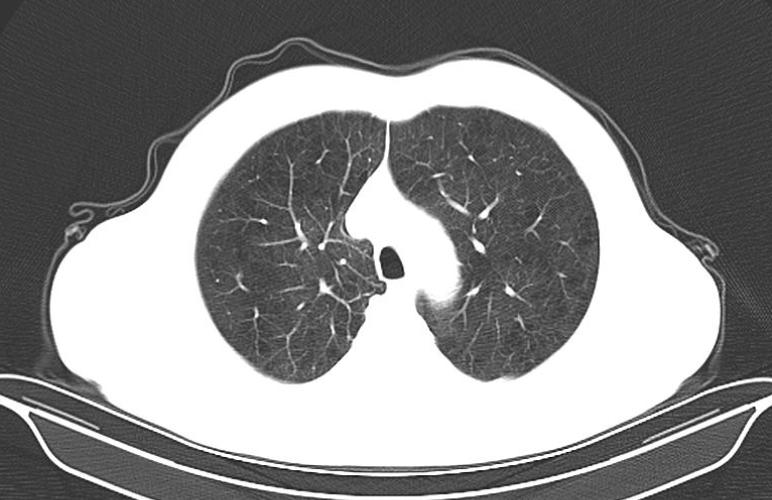
医生解读ct有差异吗,医生是怎么看懂ct的

72岁的王大爷发了几十条私信:小马大夫,我的肺CT结果出来了,上面写着一堆病:条索、钙化点、肺大泡,我还能活多久啊?
45岁的李阿姨:马医生,我查出了微小结节,看了你的文章后,我知道不用太担心了,但是还有其他的病医生没有解释,钙化斑、肺大泡,那些严重不?
前几天写了一篇关于肺结节的文章,很多粉丝发来CT报告单来给我,说自己的肺上一堆毛病,今天给大伙儿说道说道肺部CT报告上的高频词汇。
高频词汇一:条索

白色粗线就是条索
条索,在CT图像上形态类似条索状样的高密度影,说的通俗点,CT图像上的线状或者粗条状的白影就是条索。它是如何形成的呢?通常是由于成纤维细胞增生,导致纤维化,说的简单点,是因为之前肺部有炎症,现在已经痊愈,条索就是愈合后遗留下来疤痕。所以说,CT报告单上有少许条索,不必过于紧张。当然,肺间质纤维化患者会出现双肺多发粗大的条索,肺结核和一些肺部肿瘤的周边也会有条索的出现,因为这些病变同样会刺激成纤维细胞的增生,出现条索。
总结:如果报告上只是单纯报条索,那就是一道疤而已,不用担心。
高频词汇二:钙化

刚刚说到,条索就是肺部一些疾病愈合后遗留下来疤痕,那么钙化是另一种愈合后的表现形式,临床上常见于肺结核自愈的患者。专业角度解释,局部组织变性坏死的基础上,由于局部组织的理化环境改变而促使血液中钙、磷离子发生沉积,造成除了骨和牙齿外,在机体的其他组织发生钙盐沉着的现象,也称病理性钙化。也就是说:出现钙化的不止有骨头和牙齿,受伤后愈合也会出现钙化。在CT图像上,呈现出白色的点或块。报告单上有一些词汇形容钙化的大小。通常:钙化点说的是3-5毫米左右的病灶,钙化斑、钙化灶形容体积更大的钙化。
总结:单纯钙化,也是疤,同样不用担心。
高频词汇三:肺大泡
肺是由多个肺泡组成的,每个肺泡都好像一个有弹性的气球,能储存氧气,排出二氧化碳。肺大泡呢,一般继发于小支气管的肺炎或者是肺气肿,肺泡壁及间隔逐渐因泡内压力升高而破裂,肺泡互相融合形成大的含气囊腔,就像一个充满残气的塑料袋,失去了弹性。肺大泡在CT上是黑色空腔,壁细薄,多为圆形、椭圆形,大小不一。老烟民的肺部常常有很多的肺大泡!小的肺大泡本身不引起症状,有些肺大泡可经多年无改变,有些肺大泡可逐渐增大,或在其他部位又出现新的肺大泡,甚至部分肺大泡发生融合,这种情况要警惕了,因为巨大肺大泡可使肺功能发生障碍,还会有胸闷、气短的临床表现,若肺大泡突然增大破裂,可产生自发性气胸,而引起严重的呼吸困难。
总结:肺大泡不发展,也不用担心。
我是核医学马拓,关注我,轻松了解更多医学知识。
#健康真相馆##真相来了##寻找真知派##肺部检查报告# #关注新型肺炎# #我要上头条# @微头条 @头条健康 @头条健康情报局